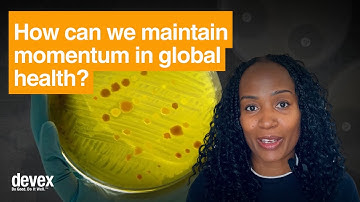

⬇ DOWNLOAD NOW
Kalau muncul iklan pop-up, tutup lalu klik tombol kembali
Download lagu Lara Downes: THE DECLARATION PROJECT in Austin TX - Leah secara gratis hanya untuk keperluan promosi. Dukung artis favorit kamu dengan membeli musik original di iTunes atau platform resmi lainnya.
 Lara Downes: THE DECLARATION PROJECT in Austin TX - Hamilton
Lara Downes: THE DECLARATION PROJECT in Austin TX - Hamilton
 Lara Downes Presents The Declaration Project
Lara Downes Presents The Declaration Project
 Lara Downes: THE DECLARATION PROJECT with the Philadelphia Orchestra, May 2025
Lara Downes: THE DECLARATION PROJECT with the Philadelphia Orchestra, May 2025
 Lara Downes: THE DECLARATION PROJECT in Knoxville TN, March 2025
Lara Downes: THE DECLARATION PROJECT in Knoxville TN, March 2025
 LFM TV - Scientology Día De Los Muertos event part 2 #LFMTV #SPTV
LFM TV - Scientology Día De Los Muertos event part 2 #LFMTV #SPTV
 Thuata Dé Danann Arrival
Thuata Dé Danann Arrival
 Adéihozhdílzi - Know Who You Are
Adéihozhdílzi - Know Who You Are
After the declaration: Turning high-level meetings into lasting momentum
After the declaration: Turning high-level meetings into lasting momentum